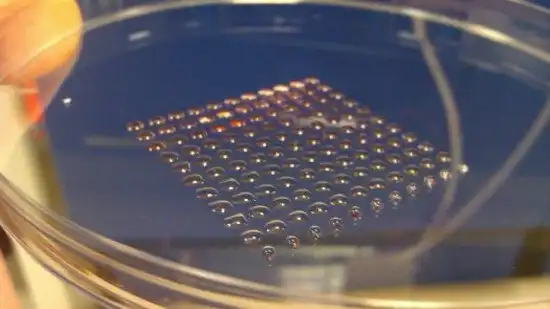

В Германии побег из тюрьмы не является незаконным
Планировать и совершать побеги из тюрем в Германии не то, чтобы разрешено, и конечно, крайне нежелательно для администрации тюрем, но не незаконно. В случае, если человек удачно совершил побег, но впоследствии был пойман, он отправляется «досиживать» свой срок, не привлекаясь к уголовной ответственности и не платя никаких штрафов. Или гуляет на свободе, пока не поймают.
Причина такой «мягкости» властей заключается в том, что немцы считают, что стремление к свободе — один из основных человеческих инстинктов, бороться с которым бесполезно и бессмысленно. Свободолюбие — такая же непобедимая тяга, как и инстинкт размножения и самосохранения, что можно доказать примером животного, пойманного и посаженного в клетку: пока оно не сломлено психологически и не приучено к неволе, животное будет совершать попытки при любой удобной возможности.
Однако за помощь при побеге полагается штраф — тюремное заключение сроком до пяти лет.
Откуда произошло слово «монета»?
Римская богиня Юнона имела титул Монета, что в переводе с латыни означает «предостерегающая» или «советница». Возле храма Юноны на Капитолии находились мастерские, где чеканили металлические деньги. Именно поэтому мы называем их монетами, а в английском языке от этого титула произошло общее название денег — ‘money’. Кстати, первоначальное значение слова «монета» вступает в силу, когда мы подбрасываем её в поисках совета.
На рисунках монеты Римской империи приблизительно 1 в.н.э. В строгом смысле слова это не деньги, а жетоны, которыми расплачивались с проститутками, но многие торговцы с удовольствием принимали их в оплату за свой товар, ведь вечером за них менялось пару часов любви. Проститутки в большинстве своем были рабынями и не понимали латинского языка, а на жетончиках было нарисовано какую именно услугу они должны были оказать клиенту.
Поцелуй в губы
Долгое время считалось, что поцелуй в губы придумали римляне за многие сотни лет до нашей эры. На самом деле римляне лишь наблюдали за насекомыми. Они поняли, что в тот момент, когда насекомые касаются друг друга губами, происходит акт щедрости и благородства, консолидирующий их общество.
Римляне так до конца и не поняли весь смысл этого прикосновения, но решили воспроизвести его для того, чтобы достичь сплоченности, свойственной муравейнику.
Поцелуй в губы имитирует трофаллаксию. Но настоящая трофаллаксия – это отрыгивание пищи из социального зоба и принесение ее в дар, в то время как человеческий поцелуй – всего лишь невнятный обмен слюной.
Человеческие эмбриональные стволовые клетки можно печатать на 3D-принтере
3D-принтер уже может производить не только технические детали или продукты питания, но и человеческие эмбриональные стволовые клетки, которые затем можно перепрограммировать в любые необходимые клетки органов и тканей.
Клетки наносятся друг на друга послойно с помощью двух типов материалов: различных видов непосредственно клеток и вспомогательных органических веществ вроде коллагена или поддерживающего гидрогеля. Этот подход помогает укрепить создаваемую конструкцию до тех пор, пока между клетками не образуются естественные связи.
В процессе печати эмбриональные стволовые клетки специально помещают в две разные ёмкости, а затем наносят на пластину по заранее подготовленной схеме слой за слоем. «Напечатанные» клетки остаются вполне жизнеспособными и сохраняют все свойства оригинальных живых клеток.
В дальнейшем новую технологию планируется использоваться для выращивания полноценных органов, пригодных для трансплантации, однако для того, чтобы вырастить таким образом живой орган вроде печени или сердца, потребуется ряд дополнительных исследований.
Эффект Паули
В мире науки, как в разных родах войск в армии, принято добродушно подшучивать над коллегами из других областей: к примеру, биологи никогда не упустят возможности посмеяться над химиками, химики — над физиками и т. д. Однако и внутри одного сектора науки также присутствует шуточное соперничество между людьми, работающими над разными направлениями: скажем, теоретики физики и экспериментаторы, проводящие свои исследования в лабораториях, никогда не упустят возможности друг друга «подколоть». Одна такая шутка закончилась выводом «Эффекта Паули», который можно сформулировать так: «Одно присутствие некоторых людей в лаборатории способно вывести из строя самые надёжные приборы».
Вольфганг Паули, 1924 год
Лабораторное оборудование должно быть специально и тонко настроено, от этого зависит точность результатов работы. Вольфганг Паули (1900—1958 гг.) — блестящий теоретик физики, лауреат Нобелевской премии за 1945-й год, «прославился» среди коллег своей удивительной неудачливостью: как только ему доводилось за какой-нибудь надобностью заглянуть в лабораторию, там обязательно что-нибудь ломалось. Разрушения после визитов Паули стали настолько привычным делом, что коллеги придумали «эффект Паули», и репутация физика-разрушителя быстро распространилась по всему научному сообществу.
Особенно удивительно то, что оборудование ломалось и сбивалось даже тогда, когда Паули и близко к нему не подходил. Известен случай, когда высокоточные приборы в лаборатории Джеймса Франка в Гёттингене внезапно без каких-либо причин перестали работать. Франк ради шутки написал письмо Паули в Цюрих, в котором описал произошедшее. В ответном письме Паули писал, что ездил проведать Нильса Бора и во время загадочного происшествия возвращался обратно поездом, который в тот день как раз совершал остановку в Гёттингене.
В другом случае над Паули решили подшутить: при помощи реле соединили входную дверь в помещении, где физик должен был читать лекцию, с настенными часами таким образом, чтобы когда Паули открыл дверь, часы остановились. Но этого не произошло: когда учёный вошёл, неожиданно отказало реле.
Конечно, эффект Паули в наше время можно отнести к научному фольклору, но всё же имейте ввиду: если вы «не дружите» с техникой, и у вас постоянно всё ломается, возможно, пора принести миру пользу и заняться теоретической физикой.
Мозг может «редактировать» полученный опыт с помощью подсознания
Уже через полсекунды после того, как объект исчезает из поля зрения, мозг может «отредактировать» связанный с ним опыт, чтобы запомнить этот объект, считают французские исследователи. Это открытие может объяснить то странное ощущение, когда вы пытаетесь вспомнить что то, что вроде бы слышали когда то, даже если сознательно вы ничего об этом не помните.
Исследование опровергает мнение о том, что мозг последовательно воспринимает сенсорную информацию, обрабатывает её, а затем осознанно извлекает из неё опыт. Следует отбросить идею о том, что сознание подобно фильму в вашей голове, с последовательной обработкой кадров, и что как только обработка выполнена, вы получаете готовый фильм, который смотрите. Редактирование полученной информации может пойти дальше. Это обусловлено особенностями нашего восприятия.
По мнению автора исследования Клэр Сержан, люди воспринимают информацию от своих органов слуха и зрения автоматически, по большей части не замечая её осознанно. Но сознание и восприятие могут оказаться сложнее, чем мы привыкли считать.
Исследователи провели эксперимент с участием 18 студентов. Участникам были показаны группы линий, входящих в круг с правой или левой стороны экрана и затем исчезавших. Иногда линии были слишком бледными, чтобы их можно было заметить осознанно, в других же случаях линии были вполне чёткими. В тех случаях, когда линии были очень бледными, исследователи специально обращали внимание участников на те места, где линии были заметны в течение короткого времени и немного затемняли круг — на полсекунды создавался контраст между кругом и фоном, а затем эти «метки внимания» исчезали.
После этого студентов попросили рассказать, что они видели. Когда исследователи спрашивали о тех местах, где появлялись линии, испытуемые чаще всего говорили, что видели их всё время вполне отчётливо. В сущности, участники испытывали ретро-восприятие, странный опыт, в котором их мозг добавил линии к их сознательной памяти уже после того, как линии исчезли.
До сих пор точно не известно, как люди могут редактировать свои сознательные мысли уже после того, как что-то увидели или услышали, однако учёные надеются, что открытие может оказаться полезным при изучении новых дисциплин — например, при изучении иностранного языка.
Собака, которая всю жизнь спасала кошек
Собака по кличке Джинни не только никогда не гонялась за кошками, но и на протяжении всей своей жизни спасала их от смерти.
Этим необычным для собаки делом Джинни начала заниматься после того, как её забрал из приюта Филипп Гонсалес. Мужчина был инвалидом и решил завести себе четвероногого компаньона. Филипп не успел подойти к клетке Джинни в приюте, как собака начала лизать ему руки. Вскоре Джинни обрела дом и доброго хозяина.
Почти сразу, как собака оказалась дома, она стала находить бездомных кошек и тех, которым требовалась помощь. Бездомных кошек Джинни удавалось приводить к дому, а раненых и больных — собака приносила Филиппу.
Первый подвиг Джинни – это спасение пятерых котят из старой трубы, где они оказались, словно в ловушке. Но позже Джинни начала находить кошек и в гораздо более опасных местах. Например, однажды собака нашла истощенного котенка в контейнере с битым стеклом. Джинни изранила до крови лапы, но все же достала беспомощное животное из контейнера. Спасенных кошек Филипп выхаживал и находил им дом, а некоторых из них он приютил у себя.
По словам хозяина Джинни, собака была готова помогать не только кошкам, но и людям. Так, когда слепой мужчина пытался перейти дорогу с оживленным движением, она встала перед ним и начала лаять, пока тот не вернулся на обочину.
Умерла Джинни 25 августа 2005 года. В память о Джинни существует фан-клуб, где можно найти истории из её жизни, видео о знаменитой собаке и фотографии с ней, а также сделать пожертвование в некоммерческий фонд помощи бездомным кошкам, который Филипп основал ещё при жизни Джинни.
Почему женщины любят сладкое?
Ведь, правда, очень редко встречаются мужчины-сластёны. Если предложить женщине выбрать любимую еду – она, скорее всего, возьмёт шоколадку, кусочек торта, фрукты. А мужчина? Он положит на тарелку мясо, колбасу или сосиски. Учёные доказали, что женскому организму сладкое часто просто необходимо, это происходит из-за воздействия половых гормонов эстрогенов на ткани головного мозга и уровень сахара в крови.
Особенно нашему организму необходимы сладости в период полового созревания, перед месячными и во время беременности. Так если иногда хочется, а вроде как нельзя, то может, можно?
Конечно можно! В разумных количествах сладости могут только помочь. Так какая от сладкого польза?
Продлевает молодость
Вы замечали, что с возрастом люди меньше едят сладкого? С наступлением менопаузы уменьшается уровень гормонов эстрогенов, вместе с этим у женщин ослабевает тяга к сладкому. Старушки-сладкоежки – большая редкость. Выясняется также, что те, кто не отказывает себе в сладком, не так подвержены процессу увядания. Конфетки и пирожные постоянно пополняют запас антиоксидантов, которые в свою очередь борются с вредными свободными радикалами. Самые мощные источники антиоксидантов из сладостей: мёд, шоколад, чернослив, изюм.
Помогает справиться с ПМС
Почему-то всегда с приближением критических дней нам хочется шоколадку или каких-то сладких фруктов. Так организм сигнализирует об изменении уровня гормонов. И не надо это желание просто заедать большим количеством обычной еды. В результате ведь всё равно трудно устоять перед конфеткой, и вы её съедите. Так, может, лучше просто предоставить организму немного сладенького, не нагружая его сверх нормы остальной обычной едой? Магний, содержащийся в шоколаде (достаточно 50 грамм, где и содержится суточная норма магния), поможет снять боли в нижней части живота. Обычный бисквит может в эти дни повысить уровень серотонина, вещества, влияющего на наше настроение.
Повышает шансы стать мамой
Диетологи советуют налегать на витамин Е, если планируешь стать мамой. Он увеличивает вероятность зачатия. Этого витамина много в подсолнечном масле и халве. Сейчас многие исключают подсолнечное масло, заменяя его на оливковое. Что ж, остаётся халва. Она, конечно, намного вкуснее!
Повышает уровень IQ
Среди продуктов, которые влияют на мозговую деятельность, лидерство удерживают сладости. На первом месте – горький шоколад. Именно горький, потому что шоколадка с орехами или молочный шоколад – это лишние жиры, которые не дадут сконцентрироваться и могут сделать вас медлительной и даже немного заторможенной. Поэтому, если нужен мозговой штурм – берём горький шоколад (а именно сахар плюс какао-масло). От нервов, между прочим, тоже помогает. Сладкое – единственная пища для мозга, так как его клетки в качестве пищи принимают исключительно глюкозу (в сутки необходимо не менее 30 грамм).
Борется со стрессом и плохим настроением
Сладости дают энергию, так необходимую в периоды, когда что-то не ладится. Сахар на 99,9% – это углеводы, а значит идеальный источник энергии. Эти углеводы – быстрое топливо, они утилизируются практически мгновенно. К таким энерджайзерам можно отнести шоколад, мёд, сухофрукты. Съев их, мы ощущаем прилив бодрости. Настроение часто напрямую зависит от энергии в нашем организме. Заряжайтесь энергией в стрессовых ситуациях, это поможет с ними справиться.
Волосатый камень
Не так давно человечество узнало для себя ещё одну историю очередного удивительного камня, которого нашли в Китае 2007 году. Оказывается, есть очень необычные камни, из которых растут волосы, почти как у человека. Камень по цвету , как серый металл, а по форме – он ровный и круглый, похожий на простой булыжник.
На нем есть тонкий слой, так называемого скальпа, который соединяет камень с волосами. Волосы серые, как седые, а по цвету как камень, растут достаточно естественно от вершины камня, длиной приблизительно 15 сантиметров, но «каменные» волосы несколько грубее человеческих. Подобную диковину нашли на берегу моря и именуется «камнем, который выращивает волосы». Пока все условия нормальные, тогда волосы продолжат расти. До этого момента было известно о 2 таких находках, и обе они сегодня находятся в Музее в Тайване.
Странный камень является экспанатом в пекинском FashlionRockCafe, который расположен в области Чжунгуань. Длина находки составляет 30 сантиметров, а ширина 20 и высота 15 сантиметров. По словам ученых, его стоимость составляет около 10 миллионов юаней (то есть 1,3 миллиона $).
Как появилась текила
Текила – национальный напиток Мексики. Иногда текилу, глубоко заблуждаясь, называют кактусовой водкой. Но текила делается вовсе не из кактусов, а из сока местной агавы (также называемого магуэй).
Агава, перебродивший сок которой используется для приготовления национального мексиканского алкоголя, имеет мясистые листья, увенчанные колючками. Поэтому, это растение семейства амариллисовых иногда называют кактусом. А вот водка – справедливое название, ведь текила, как и ее русский собрат, употребляется крепостью 40 градусов.
История текилы – это история Мексики. Древние ацтеки еще в VIII веке научились добывать из листьев агавы тягучий сладкий сок и делать из него слабоалкогольный напиток октли (позднее напиток получил название пульке). Пить пульке, кстати, формально разрешалось только раз в четыре года, на празднике в честь бога огня. В остальное время это было привилегией стариков и больных.
Вплоть до прибытия в Мексику испанцев, пульке был единственным мексиканским национальным напитком. Но, когда в 1521 году у горячих испанских конкистадоров закончился их собственный бренди, они, как носители передового опыта продвинутой в области технологий цивилизации, с помощью дистилляции получили из пульке крепкий самогон – мескаль. Таким же способом, кстати, изготавливают текилу и сегодня. После дистилляции получают напиток крепостью 55 градусов и разбавляют водой до 40.
Видимо, полученный напиток так всем понравился, что в 1600 году Педро Санчес де Тагли, маркиз Альтамир, основал первую фабрику текилы на гасиенде Cuisillos.
Популярность текилы росла очень быстро и уже в 1608 году местные правители ввели специальный налог на торговлю этим напитком. А культивация голубой агавы началась в 1758 году (автор идеи — дон Хосе Антонио де Куэрво).
Беспокойное начало XIX века (война мексиканцев за независимость, война Мексики с США) — золотое время для текилы, которая стала в это время универсальной валютой для всех воюющих сторон. А с расцветом железных дорог в 1880-х годах, текила, завоевав признание американцев, начинает завоевывать Европу. Незадолго до этого произошло разделение мескаля и текилы — подобно тому, как настоящее шампанское производят только в провинции Шампань, право называться текилой было закреплено за мескалем, производимым по особой технологии в штате Халиско, в окрестностях города Текила.
Не стоит думать, что текила и мескаль – одно и тоже. Формально, текила — это один из видов мескаля, но мескаль — не текила. И хотя у них много общего, текила и мескаль так же различны, как, например, коньяк и бренди. Текилу получают только из одного вида агавы — голубой агавы (agave blue tequilana Weber). Мескаль производится из пяти различных видов агавы. Текила дважды дистиллируется. Мескаль обычно перегоняют один раз. Мескаль производится главным образом в провинции Оахака (Oaxaca), прилегающей к Тихому океану. Текила — из северо-западного штата Халиско (Jalisco). Обычная крепость текилы 38-40%. Мескаль, как правило, немного крепче. Наконец, текила экспортируется по всему миру. Найти мескаль за пределами Мексики почти нереально.
Начало XX века, вновь неспокойного (в 1910 году в Мексике вспыхнула 10-ти летняя революция), уготовило текиле роль символа мексиканского освобождения. А последовавшая вслед за этим Великая Депрессия оставила в живых очень немногих производителей текилы, и только Вторая Мировая война, когда поставки алкоголя из Европы в Америку практически прекратились, снова вернула текиле былую популярность.
После войны появился коктейль «Маргарита» и первые правительственные стандарты на текилу.
Всемирную известность текиле принесли Олимпийские игры в Мехико в 1968 году, а в 1974 году мексиканские производители получили исключительное право на использование названия «текила» в мировом масштабе. С тех пор популярность текилы — особенно лучших сортов — во всем мире растет день ото дня, а мексиканское правительство строго следит за качеством этого символа страны. Сами же мексиканцы, в основном, предпочитают более дешевый мескаль, а в горных районах центральной Мексики и до сих пор весьма популярен пульке.
В настоящее время, правительством Мексики, которое строго контролирует производство текилы, утверждены 4 вида этого напитка: Blanco, Joven, Reposado и Anejo.
Текила Blanco, или «серебряная» (Silver) текила — прозрачная бесцветная разновидность напитка. Ее разливают в бутылки прямо после дистилляции, безо всякой выдержки.
Joven, чаще называемая Gold, или «золотая» — это подкрашенная красителем и сдобренная ароматическими добавками текила Blanco.
Reposado и Anejo — это настоящая, выдержанная в дубовых бочках текила, отличающаяся сроком выдержки. Reposado набирается дубовых ароматов от двух месяцев до года, а Anejo — от года до 10 лет. Считается, что свои наилучшие качества текила демонстрирует в 4-5 летнем возрасте.